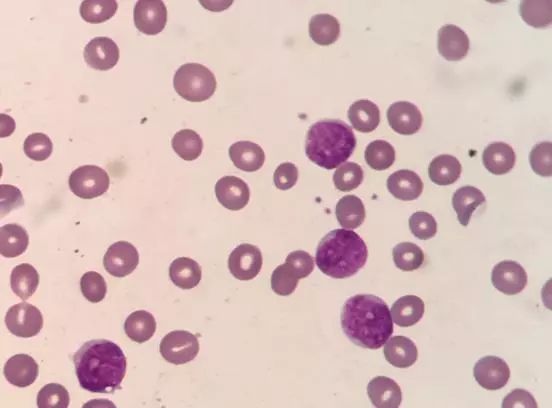

淋巴细胞增高,真的那么简单吗?
作者:张龙贤 朱英豪 南阳市第二人民医院
审校:刘佳星
患者,女性,42岁,主诉:反复发热1月余。既往史:既往体健,否认高血压、糖尿病、冠心病等慢性病史,否认肝炎、结核病等传染病史,否认外伤、手术、献血史,否认已知食物及药物过敏史。
现病史:1月余前无明显诱因出现反复发热,热峰38.2℃,伴头痛、头晕、间断胸闷、咳嗽,咳少量白色痰液,至当地诊所,按“急性上呼吸道感染”给予口服药物,效果不佳,仍反复发热。
近几日出现乏力、头晕加重,再次就诊。外院血常规检查提示白细胞计数(WBC)明显升高,血红蛋白含量和血小板计数(PLT)减低,未经诊治来我院,门诊以“白血病?”收入我院。
辅助检查:血常规检查:WBC:39.12×109/L,LYM%:97.0%,GRA%:3.0%,HGB:72.0g/L,PLT:103×109/L。散点图如下图1:

图1
凝血检查:D-二聚体明显增高为3980μg/L。
胸腹部CT平扫显示右肺下叶局部支气管扩张并可见斑块状,条片状密度增高影。左肺上叶显示少许条片影,心腔及大血管内部密度减低。
影像学意见:
1.左肺上叶少许炎症;右肺下叶局部支气管扩张伴感染。
2.心腔及大血管内密度减低,考虑贫血可能。
3.肝脏钙化灶。
患者血常规提示白细胞计数明显增高,五分类以淋巴细胞为主,且散点图显示异常,在WDF通道散点图显示存在一群异常细胞,胞体较小,与紫红色淋巴细胞群相互重叠,从横坐标SSC参数可以看出胞浆内颗粒不明显,纵坐标SFL低,触动复检规则,需推片进行人工分类。外周血涂片如下图2:

图2
进一步骨穿涂片分析,骨髓涂片如下图3:


图3
显微镜镜下可见有核细胞增生明显活跃,原始血细胞比值增高,占78.0%。此类细胞胞体较小,胞体大小均一,呈圆形或类圆形,胞浆少为灰蓝色,部分可见拖尾,胞核圆形,核染色质较细致均匀,核仁清晰可见。细胞化学染色:POX(-),ANAE(-),因条件限制,余组化染色未做。粒、红两系增生明显受抑。
外送骨髓组织病理,病理结果如下图4:

图4
外送流式结果如下图5:



图5
流式报告提示:该类细胞主要表达CD7、CD10、CD34、CD38、CD71、CD123。主要表达一些干细胞相关抗原,不表达淋系和髓系其他相关特异性抗原。之前郑大一附院流式大咖张老师的讲课,截图如下(图6),主要对MPAL和少见的白血病类型进行流式讲解。


图6
后患者转至天津血液病医院进行治疗,经追踪高度怀疑ETP-ALL。并在当地医院再次做了骨髓流式。如图7:

图7
该流式报告提示:该类异常细胞群约占88.80%,强表达CD7,表达CD43、CD38、CD33、CD99;部分表达CD10、TdT;弱表达CD123、CD56、CD71、cCD3;部分细胞弱表达CD11b;不表达CD117、HLA-DR,CD13、CD16、mCD3、CD64、CD14、CD36、CD19、ccd78a、MPO、CD2、CD5等。结论:考虑向T及NK细胞方向分化,不除外ETP-ALL,或髓系/NK前体细胞白血病。
该患者最初以急性白血病入住我院,第一次骨穿及流式结果显示该类异常细胞群为未分化的原始细胞,淋、髓待定,由流式结果首先考虑到了AUL。
后来患者转院至天津血液病医院,其流式结果显示部分淋系抗原开始弱表达,遂考虑ETP-ALL。可能该群异常细胞随时间推移开始慢慢向淋系分化,出现部分淋系标志的弱表达。
ETP-ALL是早前体T急性淋巴细胞白血病,是2016版WHO新增的一类疾病,属于ALL的高危亚型。其形态学表现无特别之处,需借助流式诊断。
其流式特点常为:CD7阳性,而CD8和CD1a阴性,髓系/干细胞抗原CD34、CD117、CD13、CD33、HLA-DR、CD11b、CD56一个或多个阳性;也可表达cCD3,CD5通常阴性。
急性未分化型白血病(AUL)起源于造血干细胞,是未分化造血细胞克隆扩增和成熟停止,白血病细胞既缺乏形态学分化特征和细胞化学反应特点,又缺乏淋巴系细胞和髓系细胞免疫表型标记的特殊类型白血病,曾被称为干细胞白血病或不能分类白血病等。
本病病因主要与电离辐射、化学因素、遗传因素等相关。其主要特点为:原始细胞无髓系分化的形态学特征;细胞化学过氧化物酶(POX)、糖原反应(PAS)、非特异性酯酶(NAE)均呈阴性反应。
一般不表达T细胞标记cCD3和髓系标记MPO,也不表达B细胞标记例如cCD22、cCD79a、无CD19强表达。缺乏其他系别如巨核细胞或浆细胞样树突细胞的特异性特征。原始细胞通常表达HLA-DR、CD34、CD38、CD7等,末端脱氧核苷酸转移酶(TdT)阴性或阳性等。
因此,日常工作中我们不能把血常规检验只是单纯的认为是数字检验,同时要结合临床,学会分析异常血常规的散点图,及时准确地筛查出异常标本,为临床提供准确的诊断依据。
来源:检验医学

